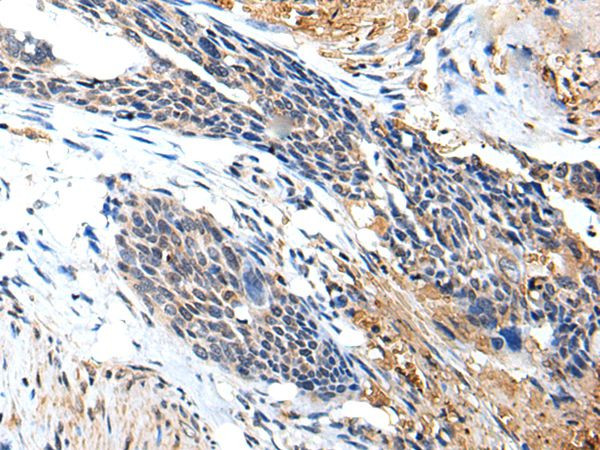
PTPRG Antibody in Immunohistochemistry (Paraffin) (IHC (P))

Search
Invitrogen
PTPRG Polyclonal Antibody
{{$productOrderCtrl.translations['antibody.pdp.commerceCard.promotion.promotions']}}
{{$productOrderCtrl.translations['antibody.pdp.commerceCard.promotion.viewpromo']}}
{{$productOrderCtrl.translations['antibody.pdp.commerceCard.promotion.promocode']}}: {{promo.promoCode}} {{promo.promoTitle}} {{promo.promoDescription}}. {{$productOrderCtrl.translations['antibody.pdp.commerceCard.promotion.learnmore']}}


Please note: We are reviewing Western blot images included in the antibody testing data in our catalog, including those provided by third parties. Unless expressly labeled or annotated as “raw-unedited”, Western blot images included in the antibody testing data in our catalog may have been edited, optimized or otherwise adjusted for presentation.
产品信息
PA5-67565
种属反应
宿主/亚型
分类
类型
抗原
偶联物
形式
浓度
规格
纯化类型
保存液
内含物
保存条件
运输条件
RRID
产品详细信息
Predicted to react with Mouse samples.
靶标信息
RPTP gamma, also known as Receptor-type tyrosine-protein phosphatase gamma, R-PTP-gamma or PTPRG is a protein tyrosine phosphatase (PTP) is a candidate tumor suppressor gene since it is located on human chromosome 3p14.2-p21, a region frequently deleted in certain types of renal and lung carcinomas. In situ hybridization analysis reveals that RPTP gamma mRNA is expressed in specific regions of the brain and that the localization of RPTP gamma changes during brain development. RPTP gamma is composed of a putative extracellular domain, a single transmembrane domain, and a cytoplasmic portion with two tandem catalytic tyrosine phosphatase domains. The extracellular domain contains a stretch of 266 amino acids with striking homology to the zinc-containing enzyme carbonic anhydrase (CAH), indicating that RPTP gamma and RPTP beta (HPTP zeta) represent a subfamily of receptor tyrosine phosphatases. RPTP gamma may have a function other than catalysis of hydration of metabolic CO2.
仅用于科研。不用于诊断过程。未经明确授权不得转售。
篇参考文献 (0)
生物信息学
蛋白别名: Protein-tyrosine phosphatase gamma; Protein-tyrosine phosphatase gamma precursor (R-PTP-gamma); R-PTP-gamma; Receptor-type tyrosine-protein phosphatase gamma
基因别名: 5430405N12Rik; AW046354; AW549872; PTPG; PTPRG; RPTPgamma
UniProt ID: (Mouse) Q05909
Entrez Gene ID: (Mouse) 19270